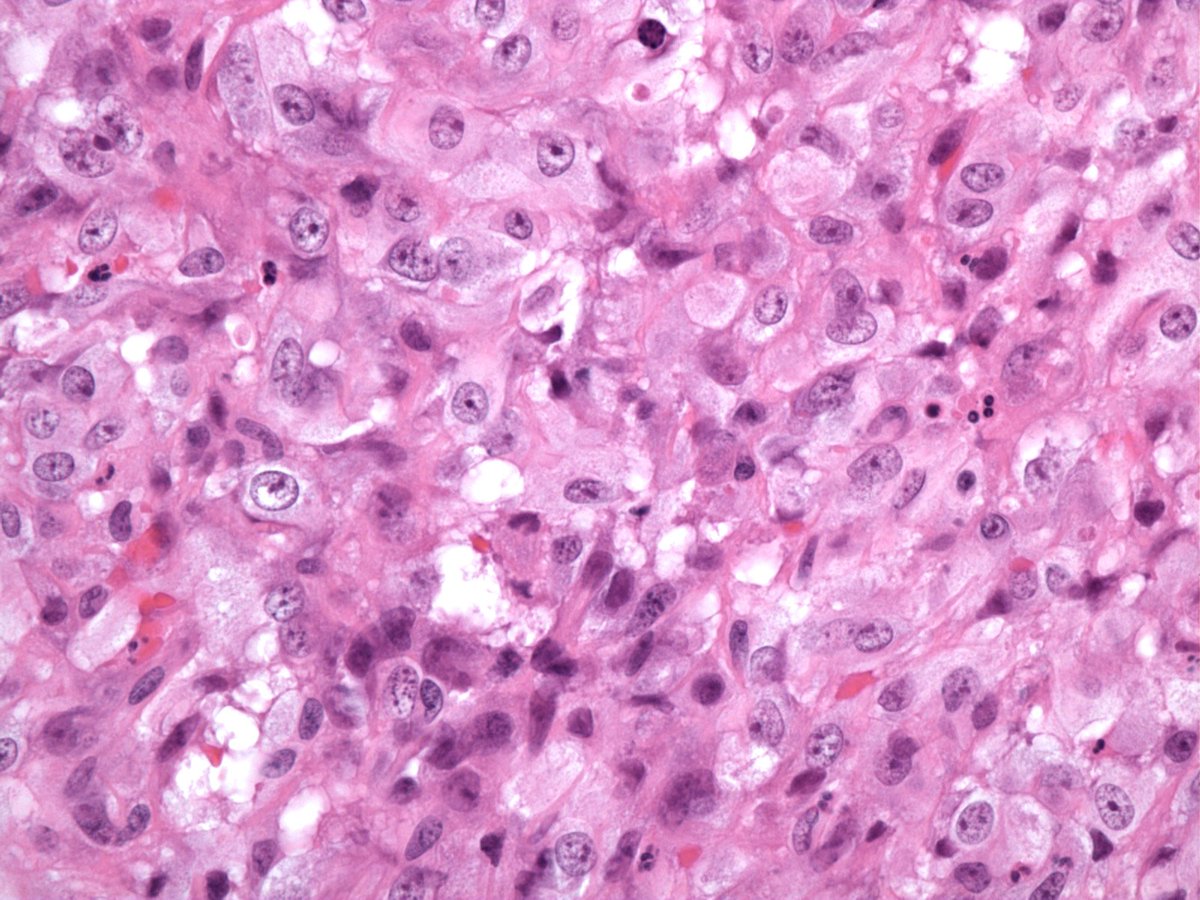
Cutaneous epithelioid angiomatous nodule. Benign vascular tumor composed of circumscribed sheet-like proliferation of epithelioid endothelial cells. First described by Brenn and Fletcher PubMed PMID: 14726818. #dermpath

Steven Billings, MD
@stevebillingsmd
Professor of Pathology @ClevelandClinic. Co-director of Dermatopathology section. Soft tissue pathologist.
ID: 729040114848960513
http://my.clevelandclinic.org/staff_directory/staff_display?doctorid=8348 07-05-2016 20:08:03
356 Tweet
3,3K Followers
267 Following

2018: what a year! Co-editing two #dermpath textbooks with friends & colleagues was a labour of love. Very proud of final products which trust will assist our colleagues & patients. Our Melanoma Institute Australia research team also recognised with awards. #melanoma #pathology



Artur Zembowicz M.D. That was a brilliant night Artur Zembowicz M.D.! Looking forward to catching up with you & other great friends in Orlando in 8-10 April 2019 when we join with my CoEditors & other outstanding contributors & present the most comprehensive review ever of the new #WHO #Dermpath #Bluebook






Brilliant to be in #Orlando presenting our #WHO Classification of #Skin #Tumours Dermpedia Courses #CME course- fabulous engaged interactive participants! #melanoma #dermpath #BCC Melanoma Institute Australia Artur Zembowicz M.D. @IanCreeUK





#pedipath for the win! Little finger nubbin on kid. I think this one is a huge scar until... Do you see it? #dermpath #BSTpath UTSW Dermatology UNM Pathology UNM Dermatology Jerad Gardner, MD Sara Shalin Joseph Susa, DO Dinesh Rakheja Dermpath-L Emily M. Altman, MD Gregory A Hosler Naiara Barbosa


EWSR1-SMAD3 rearranged fibroblastic tumor. Usually acral tumor on feet of women. Positive for ERG, negative for CD34, SMA, S100. We recently published our series in Journal of Cutaneous Pathology PMID: 32901982 Thanks to my colleagues for all their work #dermpath J Cutan Pathol


Intravascular lobular capillary hemangioma (pyogenic granuloma). Shout out to my fellow Josephine Dermawan and colleague Jennifer Ko who coauthored our series. PMID: 32496432 #dermpath #BSTpath Surgical Pathology